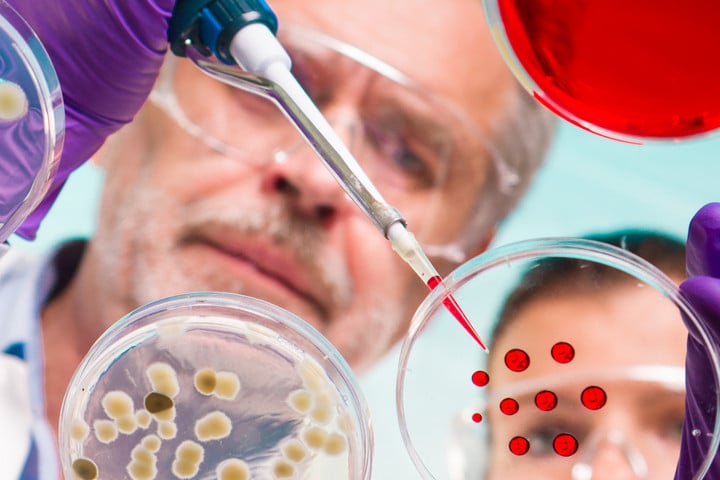
A polipok különös tudata

Tudomány
A polipok különös tudata
Az evolúció teljesen más ágán fejlődtek, mint az emlősök
A polipnak van agya, de nem olyan, mint a miénk.
A legtöbb neuront nem a fejében, hanem a karjaiban hordja mintha a gondolkodás szétterült volna a testében.
Egy polip nem egyetlen tudat, hanem nyolc független, mégis összehangolt intelligencia, amely együtt alkot egy egészet.
1. Az idegen evolúció az agy, ami máshogy nőtt ki
A legutóbbi közös ősünk egy egyszerű, féregszerű lény volt, több mint 600 millió évvel ezelőtt.
Vagyis a polip intelligenciája nem rokon az emberével függetlenül, újra feltalálta az értelmet.
A polipoknak több mint 500 millió idegsejtjük van nagyjából annyi, mint egy kutyának.
De ezeknek csak egy kis része van az agyban, a többi a karokban: minden kar önálló idegrendszerként működik, képes érzékelni, dönteni, sőt tanulni is.
Ha levágják, a kar még percekig önállóan mozog, és reagál az ingerekre.
Mintha a test maga is „gondolkodna”.
2. A bőr, ami lát – a test mint érzékszerv
A polipok bőrében fényérzékeny sejtek vannak, amelyek a szemhez hasonlóan reagálnak a fényre.
A polip tehát nemcsak látja a környezetét, hanem a bőrével is érzékeli a fényt.
Ezek a sejtek részt vesznek az álcázásban: a polip pillanatok alatt képes színt, mintázatot és textúrát váltani, hogy beleolvadjon a környezetébe.
Nem tudatos döntésről van szó, hanem automatikus, testi intelligenciáról:
a test „tudja”, hogyan kell kinéznie, anélkül, hogy az agy kiszámolná.
Ez az úgynevezett testi kogníció: az elme nem a fejben lakik, hanem eloszlik az egész testben.
3. A polip, aki tanul, álmodik és játszik
Kísérletek bizonyították, hogy a polipok felismerik az embereket,
megkülönböztetik a barátságos és az ellenséges arcokat,
és képesek megoldani logikai feladatokat például zárakat kinyitni, tárgyakat cserélni, vagy kókuszhéjat használni menedékként.
Egyes laboratóriumi megfigyelések szerint álmuk közben színt váltanak mintha álmodnának, és a testük reagálna az álomképekre.
A polip tehát nemcsak tanul, hanem belső világot is él meg.
Nem egyszerűen ösztönlény hanem önálló elme, másképp szervezve.
4. Az intelligencia, ami nem központosított
A polip „agya” hálózat, nem hierarchia.
A központi agy dönt bizonyos kérdésekben, de a karok önálló miniagyakként működnek.
Egy kar képes eldönteni, melyik tárgyat ragadja meg, hogyan fordul, és mikor enged el.
Ezzel a polip egy decentralizált idegrendszer élő példája olyan, mint egy biológiai mesterséges intelligencia, ahol minden egység önálló, mégis együttműködik.
Ahogy egy tudós fogalmazott:
„A polip teste nem az agya eszköze az agya a testének része.”
5. Az idegenszerű gondolkodás
Ha valaha idegen értelemmel találkoznánk, a polip lehet a legjobb analógia rá.
Minden szinten más, mint mi:
- teljesen más érzékelés,
- más mozgásforma,
- más idegrendszeri felépítés,
- és más kommunikációs logika.
Mégis megérti a világot, döntéseket hoz, és célokat követ.
A polip tehát idegen intelligencia a Földön nem kell az űrbe mennünk, hogy találkozzunk vele.
6. Mit tanulhatunk a polip tudatától?
A polip rávilágít arra, hogy az intelligencia nem egyetlen modell.
Nem kell agykéreg, beszéd vagy eszközhasználat ahhoz, hogy tudatosság létezzen.
Az értelem lehet elosztott, testben megnyilvánuló, mozdulatokban gondolkodó.
A mesterséges intelligencia kutatói ma épp ezt a modellt tanulmányozzák:
hogyan lehet olyan rendszert építeni, amely nem központi irányításon, hanem önszervező alrendszerek együttműködésén alapul pont úgy, mint a polipnál.
A test, ami gondolkodik
A polip emlékeztet arra, hogy az intelligencia nem kizárólag az agy privilégiuma.
Az elme lehet bőr, kar, ideghálózat vagy bármi, ami képes kapcsolatot teremteni a világgal.
Az ember az agyában él.
A polip az egész testében gondolkodik.
Talán ezért tűnik olyan idegennek:
Mert benne a tudat nem fejben születik, hanem mozdulatban, érintésben, áramlásban.
És talán ez a legnagyobb üzenete számunkra:
az intelligencia nem forma, hanem folyamat és a természet többféleképpen ismeri ezt a szót.
